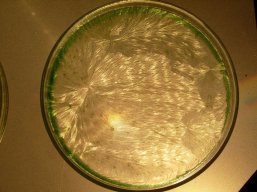
fig 1b carotte bio
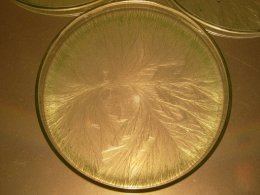
fig 9a lait bio cru
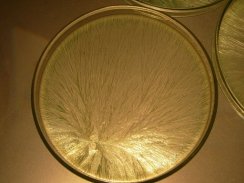
fig 9b lait bio bouilli sur gaz
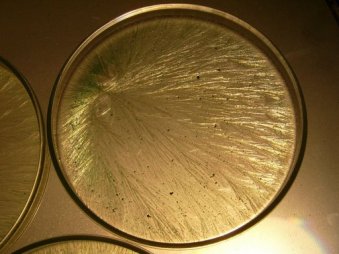
fig 9c lait bio bouilli micro

OU CRISTALLISATION AVEC ADDITIF
- Introduction :
La cristallisation sensible est une méthode de cristallographie utilisant un sel en phase aqueuse : le sel de Chlorure de Cuivre CuCl2
Cette méthode a pour objectif de mettre en évidence :
- des différences qualitatives entre des substances (liquides ou solides) identiques mais ayant subi des traitements différents : aliments (fruits, légumes, viandes, laits, vins), composts, plantes médicinales
- un risque potentiel ou une confirmation d’une pathologie installée chez une personne à partir d’une ou deux gouttes de son sang
Ce cristal, le chlorure de cuivre, existe sous forme solide dans la nature, avec des cristaux de couleur bleue ou bleu-vert. Sous forme liquide, il garde cette couleur, entre le bleu et le vert suivant sa concentration :
- bleu ciel pour les tests sur les aliments, pour une concentration de 5 a 10 %
- bleu vert voire vert pour les tests sanguins, pour une concentration de 25 %
2. Historique :
La Cristallisation Sensible (C.S.) a été mise au point par Ehrenfried Pfeiffer dans les années 20, sur la base des indications de Rudolf Steiner, le père du mouvement anthroposophique. C’est donc une approche empirique issue du milieu anthroposophe, tout comme l’agriculture biodynamique.
Steiner a donc été un peu le théoricien de la C.S., et Pfeiffer le praticien. C’est Pfeiffer qui commence à mettre en pratique les données de Steiner sur l’agriculture biodynamique, le fameux cours aux agriculteurs de Steiner datant de 1924.
Pfeiffer cherchait à mettre en évidence les forces formatrices dont parlait Steiner, les forces dites étheriques évoquées dans sa « science spirituelle ». R.Steiner avait vraisemblablement une très grande sensibilité, et dans sa philosophie, il y a au dessus du corps physique, ou plus précisément autour du corps physique, un deuxième corps qu’il a appelé le corps étherique.
Rudolf Steiner a donc suggéré à E. Pfeiffer d’étudier de près les effets d’un additif organique sur le processus de cristallisation d’un sel.
Au XXIème siècle, des chercheurs européens ont poursuivi les travaux de Pfeiffer. En ce qui concerne la recherche sur les aliments mettant en évidence des perturbations, un processus de vieillissement, il y a eu dans les années 70 Mme Magda Engquist en Suède. Et en France il y a eu surtout le laboratoire Lapats de Jean-Pierre Garel dans les années 80-90, puis Marie-Françoise Tesson [1] qui a confirmé, à la suite de M. Engquist, la mise en évidence de trois types de cristallisations des produits alimentaires issus de méthodes de culture différentes :
-
- Type racine pour l’agriculture conventionnel, agro-industriel
- Type feuille pour l’agriculture biologique, agro-biologique
- Type fleur voire fruit pour l’agriculture biodynamique

Carotte conventionnelle Carotte biologique
Figures 1 a-b
En ce qui concerne la méthode de diagnostic précoce de maladies a partir d’une ou deux gouttes de sang, les continuateurs de Pfeiffer ont été les doctoresses Frida Bessenich a Dornach (25 000 plaques), puis Alla Selawry (600 000 images !!). A partir d’une telle base de données, le Dr Selawry pouvait faire un diagnostic précoce avec une précision de 76 %, ce qui montre la validité de cette approche. Le Dr Selawry a formé plusieurs médecins français, mais aujourd’hui, seul le Goethanum peut faire un diagnostic.
3.Pratique et méthode :
Pfeiffer a testé plus de 400 sels minéraux. Finalement, le chlorure de cuivre est celui qui a donne les résultats les plus probants.
La méthode : on utilise une étuve ou l’on maintient des conditions de température et d’hygrométrie, dans l’idéal avec une régulation électronique, mais je règle personnellement la température et l’hygrométrie avec un simple thermostat. Je rencontre bien sûr parfois des difficultés techniques, mais une étuve bien équipée dans un laboratoire professionnel pourra rencontrer elle aussi des difficultés.
En fait, il est relativement facile de faire chez soi des cristallisations, avec un peu de matériel de laboratoire.
La température : entre 28 et 30 °C
L’hygrométrie : entre 58 et 62 %. Cette hygrométrie passera par un maximum au début de la cristallisation lorsque les plaques seront mises en place, car le processus de déshydratation va augmenter très vite l’humidité ambiante. Il faut de 12 à 14 heures pour une déshydratation complète. Plus ce temps de déshydratation sera long, meilleur sera le résultat.
On prépare dans des béchers les mélanges de trois éléments : l’eau distillée, l’additif organique sous forme d’extrait aqueux, et le chlorure de cuivre :
L’additif organique : c’est le produit que l’on veut étudier.
Pour les aliments, on prépare des extraits aqueux, en général a 20 % pour des légumes aqueux, c’est-à-dire 20 % de matière solide pour 80 % d’eau. Parfois, la concentration de 10 % est suffisante.
Pour les liquides, s’il n’y a pas de particules en suspension, on prélève directement 1 à 2 ml par exemple pour le vin, une infusion, un jus de fruit. Sinon, s’il y a des particules, on filtre avant de préférence avec un filtre de laboratoire, ou du papier sans chlore. Pour le lait, 0,1 ml suffise, ou alors on dilue le lait à 10 %. Le lait est une substance organique très concentrée.
Le chlorure de cuivre : c’est lui qui va former les cristaux. On ajoute 2 ml de sel cuivrique :
- pour les tests sur les aliments, à une concentration de 5 % a 10 %
- les tests sanguins, à une concentration de 25 % a 40 %
L’eau distillée : il faut prendre de l’eau bi-distillée ou distillée deux fois, car l’eau doit être la plus neutre possible. En effet, j’ai effectué des recherches avec des eaux de qualité différente avec un support neutre (caseïne), j’ai en particulier essayé de reproduire les tests du Japonais Masaru Emoto, et j’obtiens des résultats significatifs montrant que l’eau semble pouvoir s’imprégner d’une information.
Dans la pratique, dans chaque bécher, on met d’abord l’eau (2 ml), puis l’additif organique (2 ml) et enfin le chlorure de cuivre car c’est le plus cher (2 ml). On fait en général varier la proportion d’eau et d’additif organique entre 1 et 2 ml pour tester la sensibilité de la cristallisation (par exemple 1,5 ml d’additif organique avec alors 2,5 ml d’eau, puis 1,8 ml d’additif pour 2,2 ml d’eau…) pour trouver la répartition qui va donner la meilleure cristallisation. Il faut déterminer le poids de matière sèche de la substance à tester pour calculer la bonne dilution.
On agite le bécher pour que le mélange soit homogène. On le verse alors dans une coupelle : couvercle de boite de Petri, ou anneau sur une plaque de verre.
Lorsque les plaques sont mises en étuve, les conditions de température et d’hygrométrie doivent donc être au mieux de 28 °C et de 58 %. On place les plaques en notant bien leur place, et on attend en général une nuit ou plus (12 à 14 heures). Il est intéressant d’observer par la vitre la formation des cristaux.
A noter que Magda Engquist a remarqué que « le CuCl2 ne subissait aucune transformation chimique ou physique. La substance biologique de la solution ne s’intègre pas à l’aiguille de cristal, mais demeure en solution malgré son action intensive sur le processus de croissance des cristaux. Il s’agit par conséquent de transformations morphologiques des cristaux spécifiques du milieu et susceptibles de se reproduire » (Gestaltkräfte des Lebendingen, Vitorio Klostermann, 1970). Au contact d’une substance organique, les cristaux de sel cuivrique vont donc s’agencer de telle ou telle manière suivant la résistance qu’ils vont rencontrer dans le processus de formation des arborescences.
4. La lecture des cristaux :
A partir du 1er germe que nous appelons le centre germinatif, va se développer une arborescence spécifique du produit étudié. Nous dirions une signature. La forme de la construction cristallographique, les agrégats d’aiguilles cristallisées vont être typiques de la substance. Sur plusieurs cristallisations du même échantillon, nous obtenons des images qui sans être rigoureusement semblables, seront néanmoins morphologiquement très proches.
Cette image est composée d’une structure tripartite :
- 1 ou plusieurs centres germinatifs
- 1 zone intermédiaire ou se déploie la texture
- 1 zone périphérique ou s’arrête le processus de cristallisation, butant sur le bord
Figure 2 : structure tripartite (centre / zone médiane / périphérie) d’une cristallisation sensible (C.S.)
La texture va nous donner des indications sur le vieillissement et donc sur la vitalité restante du produit testé : suivant l’angle formé par les cristallisations de second ordre par exemple ; plus cet angle sera grand, plus la dégradation du produit sera élevée. La présence de tâches sur toute la surface sera un signe de décomposition et de déstructuration (figure 8c : lait au micro-ondes).
La texture sera parfois caractéristique d’une famille, par exemple de plantes aromatiques, et il y aura alors des reflets sur les cristaux. Dans tous les cas, cette texture dévoile une forme végétale, une arborescence.
La périphérie sera très large pour des produits dévitalisés (par exemple, les produits surgelés), comme si le champ (de vitalité) se restreignait. La congélation, ou pire la surgélation, est un mode de conservation dévitalisant, et c’est particulièrement visible pour une pomme de terre qui supporte mal la congélation.
La C.S. est-elle une indication de la vitalité d’un produit ? Qu’est-ce que la vitalité ? Vous verrez la différence physique entre une salade fraiche et une salade fanée : la texture de ses feuilles se défait. Et bien la cristallisation fait de même, à un niveau plus subtil. Est-ce la mise en évidence d’un processus thermodynamique, entre entropie et néguentropie (ou entropie négative caractérisant les forces du vivant) ? Vraisemblablement. Ce que l’on dénomme souvent par le terme d’ « énergétique » se rapporte à un processus de thermodynamique ou une substance vivante lutte en permanence contre l’entropie de la matière, entre chaos et harmonie. Selon moi, c’est ce que montre la cristallisation, mais c’est subjectif. Peut être met-elle aussi en évidence un champ d’énergie non objectivée à ce jour (un peu comme le champ magnétique autour d’un aimant) : un champ morphogénétique. Difficile à dire, à affirmer. Nous sommes un peu aux limites des connaissances scientifiques du vivant, et la science a bien du mal à définir la différence entre la matière inerte et le vivant. Comprend-t-elle seulement cette différence ? En est-elle capable ?
En tout cas, la C.S. est une méthode qualitative, pas quantitative. Elle ne vous dira pas combien de vitamines, de minéraux peut contenir l’aliment… Elle n’est pas objectivable par des mesures, bien que des analyses par traitement du signal après numérisation aient montré un début d’objectivation. C’est possible, mais je pense difficile de remplacer par le traitement d’image l’œil expérimenté à la lecture des cristallisations, car l’expérimentateur développera une intuition, une sensibilité, que n’aura jamais un ordinateur.
Malheureusement la méthode est critiquée non seulement parce qu’elle est issue du milieu anthroposophique, mais aussi parce qu’elle repose sur une interprétation humaine des images qui demande beaucoup d’expérience. Je pense que dans le contexte actuel du dogmatisme de la science moderne, la reconnaissance de la valeur scientifique (dans un sens élargi) de la C.S. est peut-être illusoire. Néanmoins, nous y travaillons.
Revenons à la lecture des images : vous obtiendrez une texture très détériorée avec la C.S. d’une graine sèche, avec une salade fanée, avec une légume blet, et vous le verrez tout de suite, même si vous n’avez jamais observé avant de cristallisation. Vous remarquerez tout de suite une différence.
En conclusion, pour un produit frais issu de l’agriculture biologique voire biodynamique (le top), vous verrez une belle texture de cristallisation, avec des ramifications de second ordre denses et bien serrées. Et une texture nette à la périphérie de la plaque.
Le troisième élément de lecture sur la structure tripartite de la plaque de cristallisation est le centre germinatif. C’est ce centre qui est selon moi le plus riche d’indications. En effet, se forme sera différente suivant les parties de la plante utilisées pour l’extrait aqueux :
- Centre en croix (+) pour les racines. Type racine (Figure 1.b)
- Petits centres en vacuoles disséminées sur la plaque poly centrée : avec les feuilles. Type feuille (Figure 1.a)
- Un seul centre, plus ou moins au centre, petit ou ample avec des cristallisations secondaires à l’intérieur de la vacuole, en fractales. Caractéristique des fleurs. Type fleur. En anthroposophie, on dirait que c’est le signe d’une astralisation. C’est une forme que l’on retrouve avec les produits animaux. La fleur est en fait la partie la plus animale de la plante, et d’ailleurs la partie qu’elle utilise pour communiquer avec le monde animal (pollinisation), jusqu’à imiter parfois une morphologie animale (orchidées).
Ce que l’on retrouve suivant les parties de la plante sera également différent suivant que la plante soit médicinale ou alimentaire.
Par exemple, la racine de valériane va donner le type fleur. Et c’est cette partie qui sera utilisée pour le sommeil.
Les sommités fleuries d’aubépine vont donner une forme octogonale que l’on retrouve avec la C.S. du sang d’une personne atteinte de malformation cardiaque ou susceptible de subir un infarctus ou de l’hypertension.


Infusion d’aubépine (sommités) Terrain cardiovasculaire
Figures 3 a-b
Une plante du foie va donner un centre germinatif ayant une forme en fuseau, comme le sang d’un malade ayant une insuffisance hépatique :


Infusion desmodium avec chrysantellum Fragilité hépatique
Figures 4 a-b
Cela rejoint la théorie des signatures. Nous reviendrons sur la C.S. en tant que méthode de diagnostic précoce des maladies.
Ce centre en vacuole du type fleur est donc caractéristique des fleurs, des produits animaux (miel, viande, lait), du sang, des produits végétaux issus de l’agriculture biodynamique. Si l’on se réfère à la qualité alimentaire, en France M.F. Tesson a retrouve le type racine avec des aliments agro-industriels (fig. 1a), le type feuille avec les produits issus de l’agriculture biologique (fig. 1b), et le type fleur avec donc les produits biodynamiques. Elle a mis en évidence cette typologie sur des milliers de plaques. J.P. Garel en France a également montré que plus un produit se dévitalisera, plus son centre va passer de la forme en vacuole à une forme de plus en plus simple et réduite jusqu’à la simple croix, signe de faible vitalité.
Cela donne donc un critère de qualité alimentaire pour confirmer la qualité d’un mode de culture, et indiquer à un agriculteur en reconversion où il en est, l’étape qu’il a atteinte d’un point de vue qualitatif. Ce n’est pas parce que vous êtes en production biologique que vos produits seront forcement bons : d’autres paramètres, y compris psychologiques voire plus subtils encore, jouent leur rôle dans la qualité du produit final. C’est donc un outil de développement formidable pour un producteur. Cela peut lui faire prendre conscience si le système producteur / terres et cultures / environnement est bien en synergie, s’il en émerge quelque chose. Cela peut servir de détonateur, lui permettre de prendre conscience d’un problème. Pour un producteur qui soumet ses produits au test de la cristallisation sensible, il peut y avoir de bonnes ou de mauvaises surprises.
Premier point donc, la cristallisation sensible est un outil d’analyse qualitative, pour les composts, les aliments, les plantes médicinales.
5. Une méthode de diagnostic précoce :
Deuxième point, pour les plantes médicinales et le sang humain ou animal, j’ai évoqué des formes spécifiques qui apparaissaient au niveau du centre germinatif, des vacuoles. Ces formes apparaissent dans des secteurs spécifiques des plaques de C.S. (correspondant à la position des organes d’un homonculus allongé sur le dos), et chaque forme géométrique correspond à un organe spécifique. Les études effectuées pendant tout le siècle dernier par des médecins allemands mais également français sur le sang de milliers de malades ont pu le confirmer :
-
- Polygone pour le cœur
- Trigone pour les reins
- Rosettes pour l’utérus
- Fuseau pour le foie, la vésicule biliaire
- Eventail pour le pancréas
- Forme en U pour le poumon

Figure 5 : distribution des formes spécifiques d’organes sur une plaque de cristallisation

Figure 6 : formes spécifiques d’organe
Une personne malade, ou une personne susceptible de développer plus tard une pathologie de tel ou tel organe, présentera la même cristallisation. Cette méthode permet donc de tester la susceptibilité morbide d’une personne.
L’intérêt majeur de la cristallisation sensible réside dans la possibilité pour les médecins d’établir ainsi un diagnostic précoce à partir d’un simple prélèvement de sang à la pulpe du doigt, ou même à partir d’urine, par exemple avant qu’un cancer ou un diabète soit détectable. Mais attention, la pathologie est soit déjà installée, soit en potentiel seulement : si la personne change des éléments de sa vie, son alimentation…, elle pourra selon moi éviter que cette pathologie s’installe, s’incarne.
Un être humain en parfaite santé aura une cristallisation rayonnante, sans vacuoles, ce qui est possible avec un jeune enfant par exemple.
Par ailleurs, lorsqu’une forme d’organe apparait, suivant la gravité du mal, une forme spécifique à la pathologie viendra se superposer à la forme d’organe :
- Une étoile s’il y a inflammation
- Une croix de Malte s’il y a tuberculose
- Une vacuole fermée s’il y a une tumeur bénigne
- Cette vacuole va s’ouvrir plus largement, et former une barre transverse souvent du côté le plus proche du centre : cancer

Figure 7 : formes spécifiques : pathologies – organes
La barre transverse peut se retrouver ou non sur un organe. Sur la texture, cela signifie qu’il y a risque de cancer, que le terrain de la personne est potentiellement cancéreux, mais sans que l’on connaisse l’organe qui a le plus de risque d’être atteint.
On retrouve cette forme de barre transverse avec des jeunes feuilles de gui. Il y a d’ailleurs analogie entre le mode d’alimentation du gui sur un arbre (hémi-parasite), et celle d’une tumeur. Justement, la médecine anthroposophique utilise du gui fermenté en injection contre les pathologies cancéreuses, avec un certain succès.
Pour ma part, je recherche depuis quelques années les points de convergence entre l’effet Kirlian, l’iridologie, la cristallisation sensible, la pulsologie chinoise et la bio-électronique de Vincent. Un exemple : une personne que je connais qui a fait une cristallisation montrant la forme du pancréas, a sur l’iris gauche justement une tache sur la zone pancréatique. Pourtant, aucun signe clinique n’indique aujourd’hui une sensibilité diabétique, mais je lui ai conseillé de demander à son médecin traitant une analyse de glycémie.
Point important : seul un médecin est habilité à demander une analyse par cristallisation sensible. Et seul un laboratoire d’analyses biologiques est habilité à réaliser une analyse de sang, pas un médecin. Cette configuration très cloisonnée va à l’encontre du suivi de la santé des personnes.
6. Conclusion
La cristallisation sensible est une approche qualitative riche d’enseignements,
-
- que ce soit pour évaluer la qualité de l’alimentation, les processus de culture, l’utilisation des plantes médicinales. Vu l’état de dégradation de l’environnement, de l’alimentation, de la santé, elle permet d’objectiver ce qui est bon pour nous et pour la planète, et devrait nous permettre de prendre conscience de nos erreurs. L’exemple ci-dessous montre les différences qualitatives entre du lait biologique cru, du lait biologique bouilli sur le gaz, et du lait biologique bouilli au four à micro-ondes (tâches, zones floues, indice d’une déstructuration de la substance).

Lait biologique cru Lait biologique bouilli sur gaz
Lait biologique bouilli au four à micro-ondes
Figures 8 a-b-c
-
- ou que ce soit comme méthode de diagnostic précoce et de suivi d’une maladie, notamment en terme de cancer. Elle peut mettre en évidence une pathologie bien avant qu’elle soit détectable par les analyses actuelles. Or, on sait que cette terrible maladie est déjà bien avancée lorsqu’elle est détectée : une tumeur de 1 cm3 contient déjà un milliard de cellules cancéreuses et a environ 8 ans : le processus invasif est déjà bien engagé. Compte tenu de la forte progression de cette maladie, il est particulièrement regrettable que cette méthode ne soit pas plus reconnue
L’auteur : ingénieur hydrodynamicien, naturopathe, herboriste, pratique l’énergétique traditionnelle chinoise. Coordonnées : Thierry FOLLIARD 01 47 07 39 79, 7 rue Vulpian 75 013 PARIS, tfnaturo@gmail.com. Mobile : 07 83 89 99 79 Egalement en Basse-Normandie, Les touches 61 190 Tourouvre, 02 33 85 48 69
Thierry FOLLIARD a remonté en 2010 un laboratoire de recherche en cristallisation sensible en Basse –Normandie, et pratique cette méthode depuis 2005.

Figure 9 – laboratoire de cristallisation en Basse-Normandie
Bibliographie :
[1] Cristaux sensibles, contribution théorique et pratique à une science du vivant – Marie-Françoise Tesson & Miguel Angel Fernandez Bravo, éditions du Fraysse, Monclar de Quercy
[2] Cristallisation avec additif, cas particulier du chlorure cuivrique et de ses
applications, Jean-Georges Barth – revue Phytothérapie (2004) Numéro 6: 183-190
© Springer 2004
bonsoir THIERRY FOLLIARD
J’aimeJ’aime